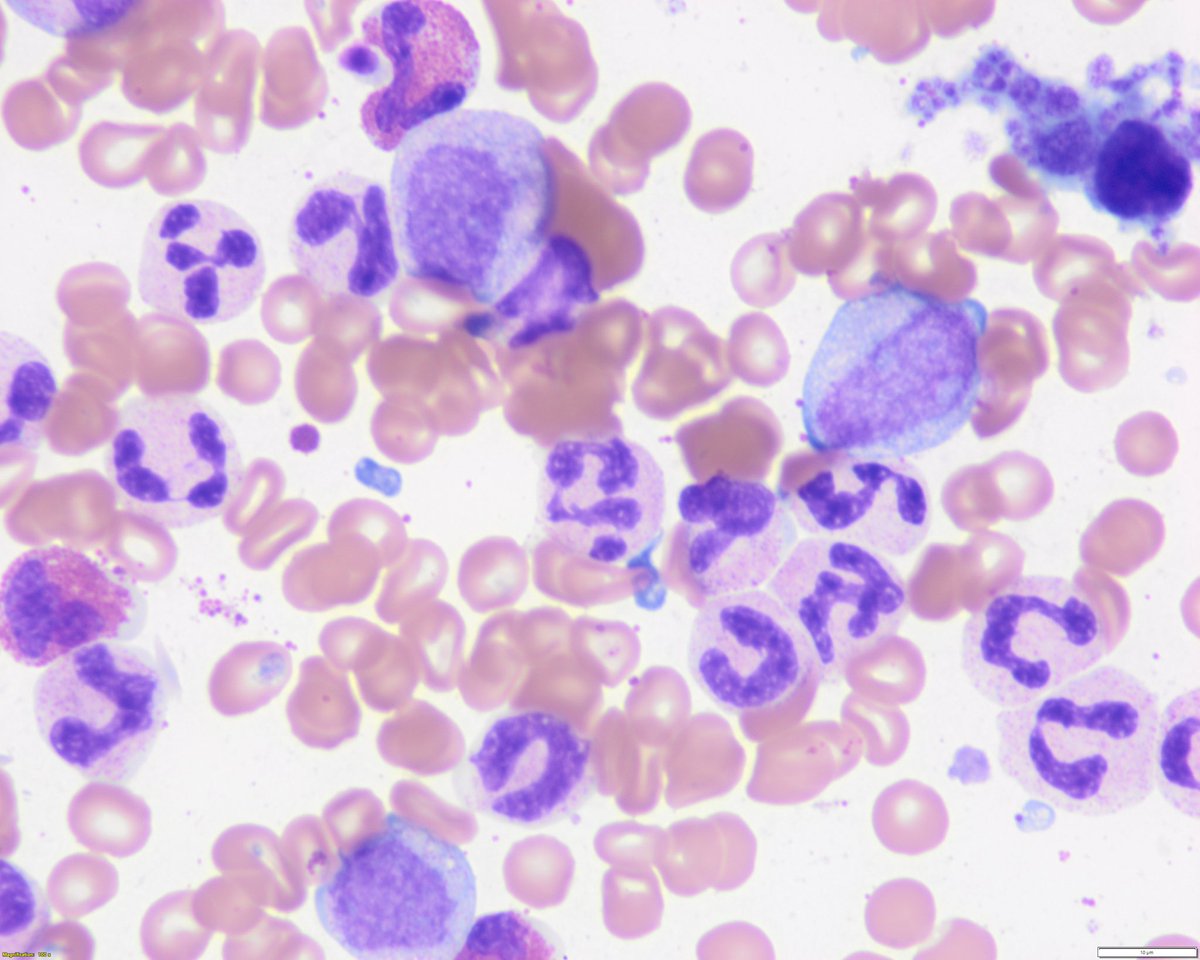
Sanam Loghavi, MD صنم لغوی 🔬🧬 tweet media
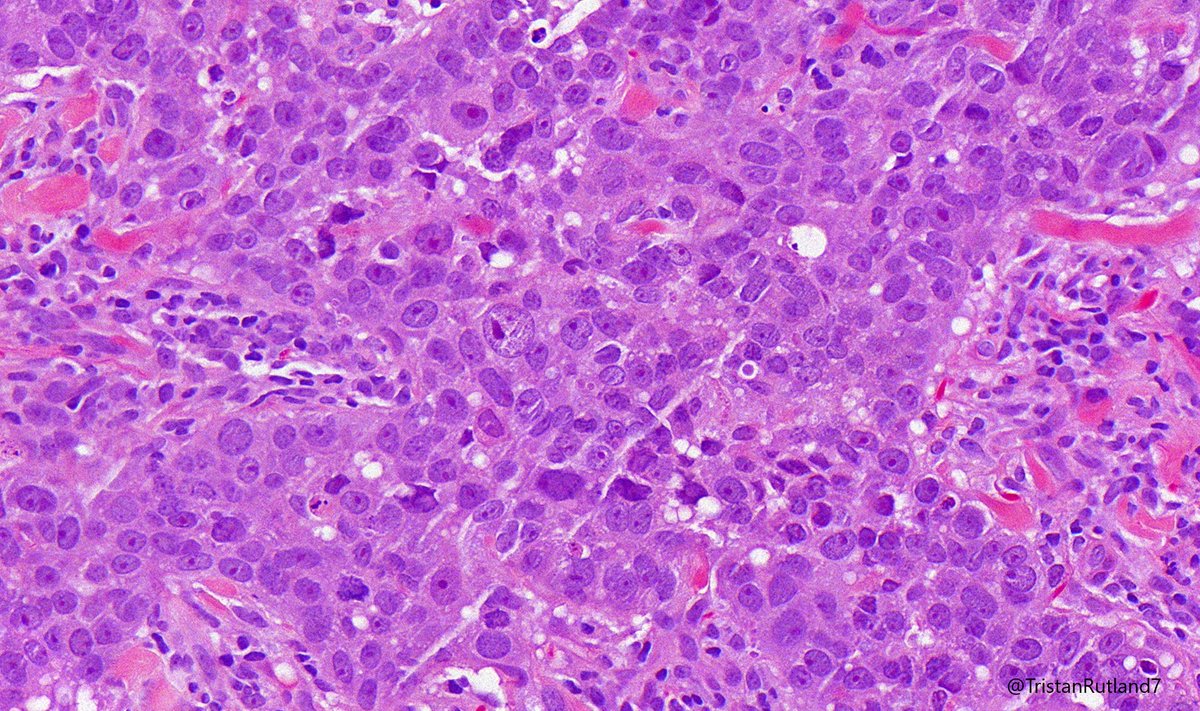
Tristan Rutland MBBS FRCPA IFCAP tweet media

Anwar Rjoop, MD retweetledi
Anwar Rjoop, MD
365 posts

Anwar Rjoop, MD
@AnwarRjoop
Pathologist at UAMS
Little Rock, AR Katılım Şubat 2016
197 Takip Edilen739 Takipçiler
Anwar Rjoop, MD retweetledi

Wow #hemepath ⬇️
Dan Graham@DanGrahamMD
@AkgulMD @Williamson_SR @slusagar @rovingatuscap @priyaraomd Okay, I overreacted. I take it all back. This is a ridiculously awesome case!!! It indeed IS metastatic RCC in a background of (what I think will eventually be diagnosed as) an MDS/MPN overlap. Just, wow. check out these stains, and my thought process to follow...

Happy to attend The Seventh International Congress for the Jordanian Society of Pathologists-Jordan
Dr.Mirza is speaking virtually @KMirza @jordanian society of pathology


English
Anwar Rjoop, MD retweetledi

#TipoftheWeek Set a plan for supervising and teaching residents. Follow these tips to help ease that transition and excel when shaping your future colleagues as well as the pathology profession.
fal.cn/3zBbf

English
Anwar Rjoop, MD retweetledi

📢 Our new article collection 'Process-based and Informatics-enabled Regulatory Healthcare' is open for submissions!
Hosted by Mohammed Odeh, Asem Mansour, Wael Kafienah & Anwar Rjoop @AnwarRjoop
Contribute or find out more here➡️fro.ntiers.in/55478
#RegulatoryHealthcare

English
Anwar Rjoop, MD retweetledi
Anwar Rjoop, MD retweetledi

(1/10) 15 y/o M -> Rx: well-circumscribed lytic expansile mass, metaphysis of distal femur 🦴
MRI: fluid-fluid levels.
Your diagnosis on these 2 high power images?
Follow the 🧵👇🏽 for a poll & a short tweetorial.
#BSTPath #PathTwitter #bstpathpodcast #pathresidents #pathfellows


English
Anwar Rjoop, MD retweetledi

25 yo woman with anterior abdominal wall mass. Core needle biopsy. Your diagnosis? Answer: kikoxp.com/posts/10656. Video about this entity: kikoxp.com/posts/4072. #BSTpath #pathologists #pathology #pathTwitter




English
Anwar Rjoop, MD retweetledi

Happy FNA Friday! This is an FNA of a pancreatic head mass. What is your diagnosis? #cytology #GIPath #pathology 1/


English
Anwar Rjoop, MD retweetledi

نزولاً عند رغبة الكثير ممن يرغب في الاستفادة من المؤتمر.. قررت اللجنة المنظمة أن المؤتمر سيكون في بث حي ومباشر للفعالية مجاناً للجميع ولكن بدون رصيد الساعات التعليمية، ومن يرغب في الحصول على الساعات التعليمية عليه التسجيل في المؤتمر.
موفقين جميعاً 💐
us06web.zoom.us/webinar/regist…
العربية

@eva_wojcik @LoyolaHealth @loyolapathology @CAPFndn @MayaAtCAPFdn Congratulations @eva_wojcik well deserved
English
Anwar Rjoop, MD retweetledi
Anwar Rjoop, MD retweetledi
Anwar Rjoop, MD retweetledi

Pathologists specializing in Transfusion Medicine provide direct patient care and work with all clinical specialties! They oversee product testing to ensure safety and determine the appropriateness of products for transfusion. #FeatureFriday #PathTwitter #MedStudentTwitter

English
Anwar Rjoop, MD retweetledi

@AaronGoodman33 Rituximab-Associated Progressive Multifocal Leukoencephalopathy
JC virus DNA in the cerebrospinal fluid
Plasma exchange
ncbi.nlm.nih.gov/pmc/articles/P…

Română
Anwar Rjoop, MD retweetledi
Anwar Rjoop, MD retweetledi
Anwar Rjoop, MD retweetledi